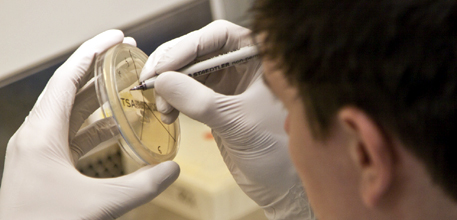

Laboratory team
The laboratory team provide quality assured sample handling, processing and analysis.
We respond rapidly to the needs of study sponsors and studies, thanks to flexibility in resources and processes.
Gavin Babbage, laboratory manager
Gavin manages the CRF laboratory and personnel, primarily overseeing the laboratory sample processing for large commercially funded projects and providing technical laboratory support for all projects that use the facility, ensuring that all sample processing strictly adheres to all MHRA,GCP and GLP guidelines.